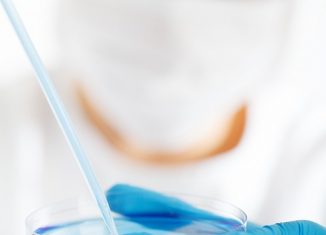

Study reveals environment and behavior contribute to 80 percent of cancers
Environmental exposures and behaviors have a huge role to play in the development of a vast majority of cancers. Quantitative evidence proving the same...
Stereotypes around aging can negatively impact memory and hearing
Old age is typically associated with the loss of mental capabilities. But, a new research led by researchers at the University of Toronto has...
Stem cells likely to be safe for use in regeneration medicine, study confirms
In a study published recently in the journal Cell Stem Cell, it has been revealed that Cambridge researchers have found the strongest evidence to...
Scientists reveal new phase of HIV infection
A new life cycle stage of HIV infection has been identified by researchers at the University Of Massachusetts Medical School with the help of...
Scientists identify molecule that appears to fuel deadly genetic illness, Fanconi anemia
Fanconi anemia is a complex genetic disorder that is responsible for birth anomalies, organ damage, anemia and cancer. Researchers working on this condition have...
Scientists identify a neural population highly selective for music
For long scientists have wondered if there is some neural mechanism in the human brain that is specific to music perception. Finally, the neuroscientists...
Scientists Grow Functional Vocal Cord Tissue in the Lab
In a report published recently in the journal Science Translational Medicine, it was revealed that scientists at the University of Wisconsin-Madison have succeeded in...
Scientists find key driver for treatment of deadly brain cancer
Glioblastoma multiforme is a quite a deadly form of brain cancer. Typically, the maximum lifespan of person with this form of brain cancer after...
Hope for Halitosis: What’s Causing Your Bad Breath?
Waking up with "morning breath" after a night on the town is one thing, but when suffer from permanent bad breath as a result...
New Mechanism for Aspirin’s Role in Cancer Prevention
It has been known for a while that aspirin has the properties to reduce the risk of colorectal cancer as well as some other...